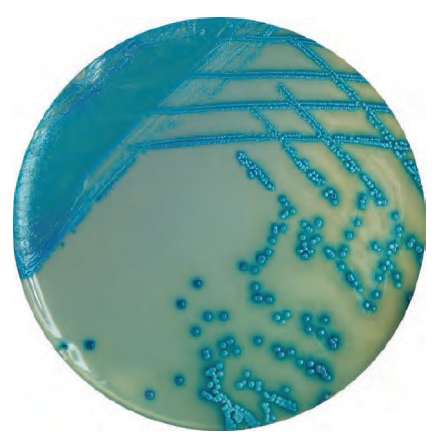
HiMedia的金黄色葡萄球菌显色培养基-威正翔禹|缔一生物

北京缔一生物科技有限公司品牌商
9 年
手机商铺
商家活跃:
产品热度:
- NaN
- 0
- 0
- 1
- 0
推荐产品
公司新闻/正文
HiMedia的金黄色葡萄球菌显色培养基-威正翔禹|缔一生物
340 人阅读发布时间:2018-05-18 16:21
金黄色葡萄球菌主要存在于人和动物的鼻腔、咽喉、头发和皮肤上。它是常见的病原菌。它能产生肠毒素,而且它很容易转移到食物上,成为食物中毒的原因。金黄色葡萄球菌的分离和计数主要是用Baird-Parker琼脂(下图)。Baird-Parker琼脂含有甘氨酸和氯化锂,能抑制其他菌的生长,而含有的丙酮酸钠,则促进金葡菌的生长。金葡菌表现为黑色小菌落,有白边和一圈透明带。Baird-Parker琼脂主要是选择性分离培养基。它有两个局限:一是金葡菌之外的菌也可能生长;二是还需要进一步的进行生化鉴定。用它培养通常要48小时。

知名微生物产品公司HiMedia生产的金黄色葡萄球菌显色培养基(货号M1837),是一款独特的产品,具有更多的优势和自己的特色。该培养基推荐用于食物中的凝固酶阳性葡萄球菌的分离和计数,并且在24小时内出结果。它也含有丙酮酸钠和氯化锂,同时具有高浓度的氯化钠,它有助于抑制伴随的微生物群落。而添加多粘菌素B硫酸盐有助于限制革兰氏阴性菌如大肠杆菌和铜绿假单胞菌的生长。
在该显色培养基上,金黄色葡萄球菌、腐生性葡萄球菌均为蓝色菌落(下图),能旺盛生长,而蜡样芽孢杆菌、表皮葡萄球菌、粪肠球菌、大肠杆菌都被抑制生长。发现可疑菌落后,也仍然需要进行生化鉴定。该显色培养基还有个好处是无须高压灭菌,因而减少了工作量。
有报道发现,Baird-Parker平板上的甘氨酸会抑制某些金黄色葡萄球菌菌株的生长,而在显色培养基上这些菌株能够生长,因此建议为保证食品安全国家标准检验方法 GB 4789.10—2010对不同金葡菌计数的覆盖性,计数检验过程中应使用两种或两种以上金葡菌选择性平板。